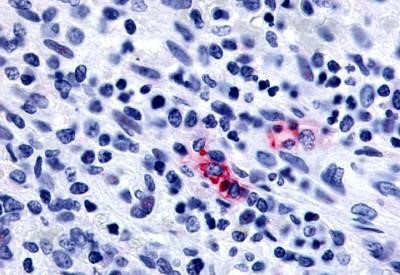
P2Y13 Antibody in Immunohistochemistry (Paraffin) (IHC (P))
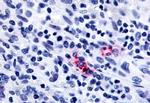
P2Y13 Antibody in Immunohistochemistry (Paraffin) (IHC (P))

Search
Invitrogen
P2Y13 Polyclonal Antibody
{{$productOrderCtrl.translations['antibody.pdp.commerceCard.promotion.promotions']}}
{{$productOrderCtrl.translations['antibody.pdp.commerceCard.promotion.viewpromo']}}
{{$productOrderCtrl.translations['antibody.pdp.commerceCard.promotion.promocode']}}: {{promo.promoCode}} {{promo.promoTitle}} {{promo.promoDescription}}. {{$productOrderCtrl.translations['antibody.pdp.commerceCard.promotion.learnmore']}}
产品信息
PA5-34086
种属反应
宿主/亚型
分类
类型
抗原
偶联物
形式
浓度
规格
纯化类型
保存液
内含物
保存条件
运输条件
RRID
产品详细信息
Percent identity with other species by BLAST analysis: Human, Gorilla, Gibbon, Monkey, Panda (100%) Marmoset, Elephant, Bovine, Rabbit (94%).
靶标信息
The product of this gene belongs to the family of G-protein coupled receptors. This family has several receptor subtypes with different pharmacological selectivity, which overlaps in some cases, for various adenosine and uridine nucleotides. This receptor is activated by ADP.
仅用于科研。不用于诊断过程。未经明确授权不得转售。
篇参考文献 (0)
生物信息学
蛋白别名: G protein-coupled receptor 86; G-protein coupled receptor 86; G-protein coupled receptor 94; P2Y purinoceptor 13; P2Y13; purinergic receptor P2Y, G-protein coupled, 13; unnamed protein product
基因别名: FKSG77; GPCR1; GPR86; GPR94; P2RY13; P2Y13; SP174
UniProt ID: (Human) Q9BPV8
Entrez Gene ID: (Human) 53829